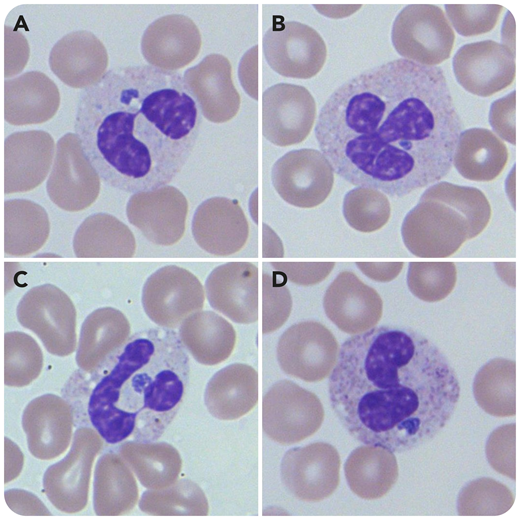
A 73-year-old Wisconsin woman was hospitalized with several days of intermittent fevers and fatigue. A complete blood count revealed pancytopenia with a white blood cell count of 2.4 × 109/L, hemoglobin 12.4 g/dL, platelets 37 × 109/L, and mean corpuscular volume 86 fL. A peripheral smear revealed numerous basophilic dense morulae within the cytoplasm of neutrophils, highly suggestive of anaplasmosis (panels A-D: Wright-Giemsa stain; 100× objective lens; total magnification ×1000). Also noted were pseudo–Pelger-Huët bilobed neutrophils, a phenomenon which is increasingly recognized in cases of anaplasmosis.

A 73-year-old Wisconsin woman was hospitalized with several days of intermittent fevers and fatigue. A complete blood count revealed pancytopenia with a white blood cell count of 2.4 × 109/L, hemoglobin 12.4 g/dL, platelets 37 × 109/L, and mean corpuscular volume 86 fL. A peripheral smear revealed numerous basophilic dense morulae within the cytoplasm of neutrophils, highly suggestive of anaplasmosis (panels A-D: Wright-Giemsa stain; 100× objective lens; total magnification ×1000). Also noted were pseudo–Pelger-Huët bilobed neutrophils, a phenomenon which is increasingly recognized in cases of anaplasmosis.
Concurrent polymerase chain reaction assay performed on the patient’s peripheral blood was positive for the bacterium Anaplasma phagocytophilum. The patient was started on doxycycline 100 mg twice per day for 10 days, resulting in clinical improvement. The patient denied definitive tick exposure but did own dogs that frolicked in the woods.
A 73-year-old Wisconsin woman was hospitalized with several days of intermittent fevers and fatigue. A complete blood count revealed pancytopenia with a white blood cell count of 2.4 × 109/L, hemoglobin 12.4 g/dL, platelets 37 × 109/L, and mean corpuscular volume 86 fL. A peripheral smear revealed numerous basophilic dense morulae within the cytoplasm of neutrophils, highly suggestive of anaplasmosis (panels A-D: Wright-Giemsa stain; 100× objective lens; total magnification ×1000). Also noted were pseudo–Pelger-Huët bilobed neutrophils, a phenomenon which is increasingly recognized in cases of anaplasmosis.
Concurrent polymerase chain reaction assay performed on the patient’s peripheral blood was positive for the bacterium Anaplasma phagocytophilum. The patient was started on doxycycline 100 mg twice per day for 10 days, resulting in clinical improvement. The patient denied definitive tick exposure but did own dogs that frolicked in the woods.
For additional images, visit the ASH Image Bank, a reference and teaching tool that is continually updated with new atlas and case study images. For more information, visit http://imagebank.hematology.org.